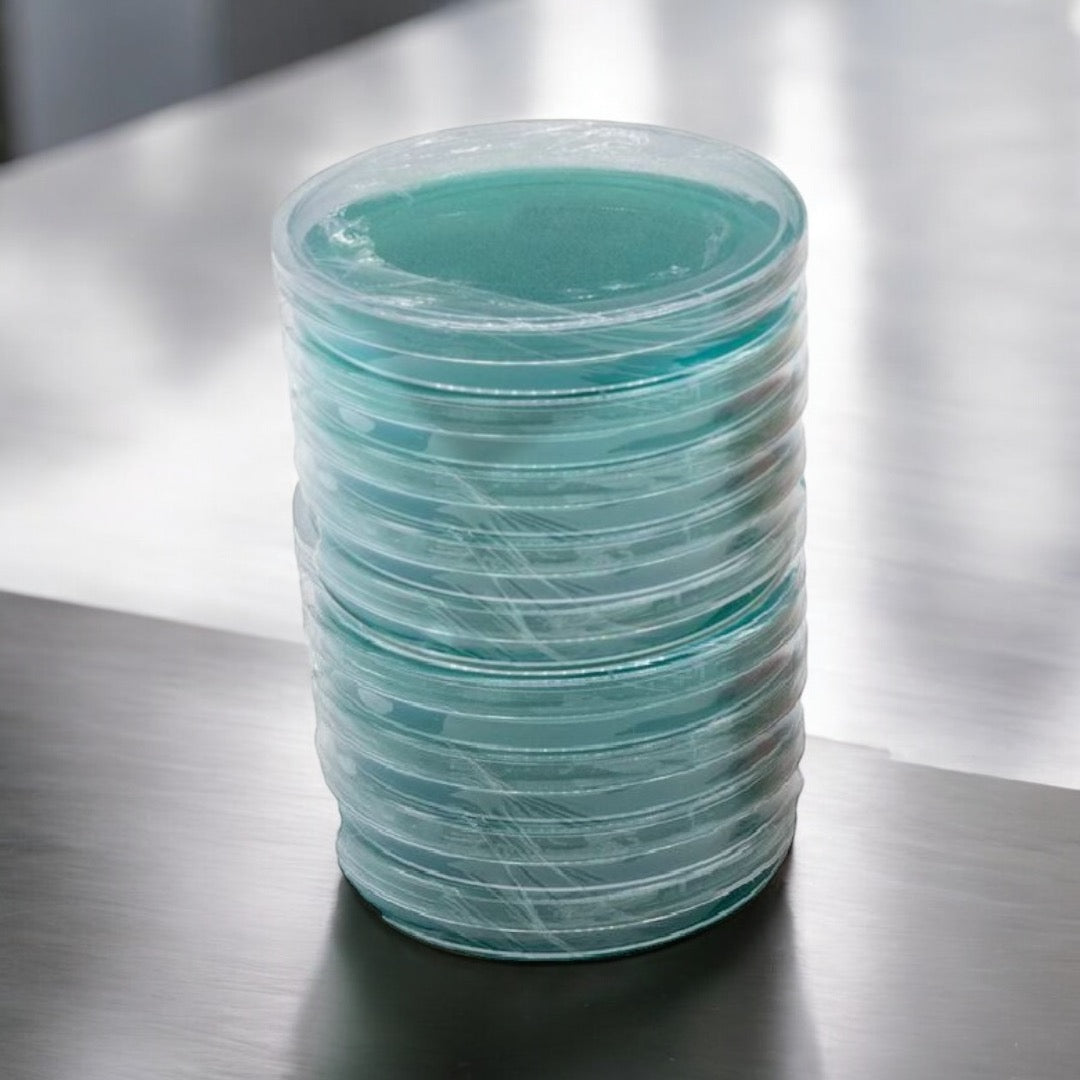

Premium Sterilized Sorghum Yeast Extract (SYA) Agar Plates - 10 Pack
Introducing Microppose Sorghum Yeast Agar (SYA) Plates – 10 Pack, the ideal choice for mycologists and mushroom enthusiasts seeking a reliable, nutrient-rich medium to cultivate mycelium. These professionally prepared SYA plates feature a carefully balanced blend of sorghum syrup and yeast extract, and peptones offering an optimal environment to support robust mycelial growth across a variety of fungal species. These plates enhance the rhizomorphic growth and are ideal for 2nd or 3rd transfers.
Key Features:
- High-Quality Nutrients: Crafted with premium sorghum syrup and yeast extract, these plates provide essential sugars, amino acids, and minerals to fuel mycelial development.
- Enhanced Rhizomorphic Growth - This blend is known for this sought after growth pattern.
- Pre-Poured & Sterile: Each plate is expertly sterilized and poured, ready to use right out of the pack to save you time and minimize contamination risk.
- Consistent, Reliable Growth: Designed for excellent nutrient retention and even spreading, allowing your cultures to flourish.
- 10-Pack Convenience: Ideal for small- to medium-scale projects or experiments, offering flexibility and convenience in your mycology work.
Whether you're isolating a strain, testing spore viability, or expanding cultures, these SYA plates deliver consistent results. Perfect for home or lab use, this 10-pack ensures you always have quality plates on hand for your growing needs. Unleash your mycological potential with plates that help you cultivate success!
Premium Sterilized Sorghum Yeast Extract (SYA) Agar Plates - 10 Pack